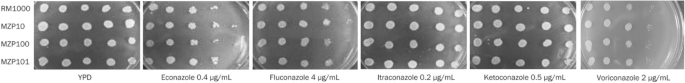
figure a

Correction to: Acta Pharmacologica Sinica https://doi.org/10.1038/aps.2010.232, published online 5 April 2011
In Figure 3A, an error was found in the published picture for the voriconazole 2 µg/mL group. One of the pictures in the econazole 0.4 µg/mL group, captured under different lighting conditions but on the same dish, was mistakenly included. We have rigorously reviewed the original data and request a correction for the image representing the voriconazole 2 µg/mL group in Figure 3A. The authors declare that these corrections do not affect the results or conclusions of this paper. We also declare that there is no duplication of images from other publications; the error was purely due to an incorrect image being used. We apologize for any inconvenience caused to the journal and readers.
Author information
Authors and Affiliations
Corresponding authors
Rights and permissions
About this article
Cite this article
Jia, Xm., Wang, Y., Zhang, Jd. et al. Author Correction: CaIPF14030 negatively modulates intracellular ATP levels during the development of azole resistance in Candida albicans. Acta Pharmacol Sin 46, 794 (2025). https://doi.org/10.1038/s41401-024-01391-9
Published:
Version of record:
Issue date:
DOI: https://doi.org/10.1038/s41401-024-01391-9